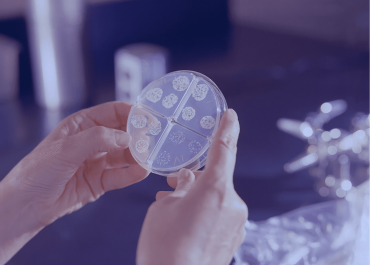
Какие анализы сдавать женщине, чтобы понять, сможет ли она забеременеть и родить?

Опыт
Наша философия – индивидуальный подбор лучших европейских практик обследования и терапии для каждого пациента.
Мы создали Институт репродуктологии в Ташкенте и объединились в команду для достижения лучшего результата! Каждый специалист IMC влюблен в свою профессию и более много лет успешно работает в сфере практического здравоохранения.